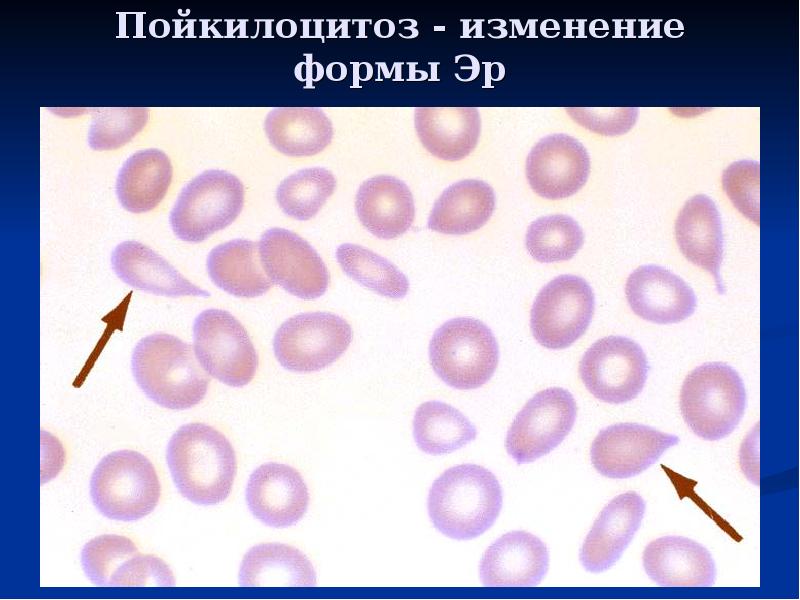
Пойкилоцитоз - изменение формы Эр
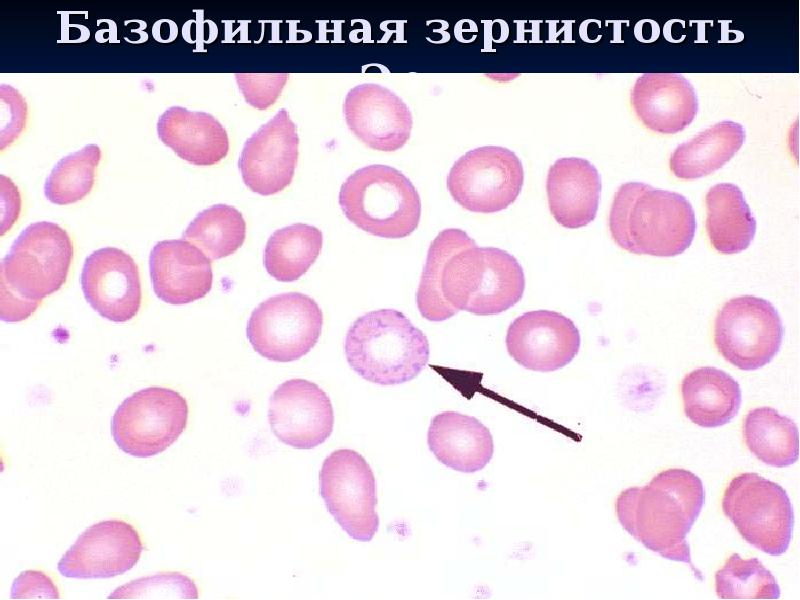
Базофильная зернистость Эр.
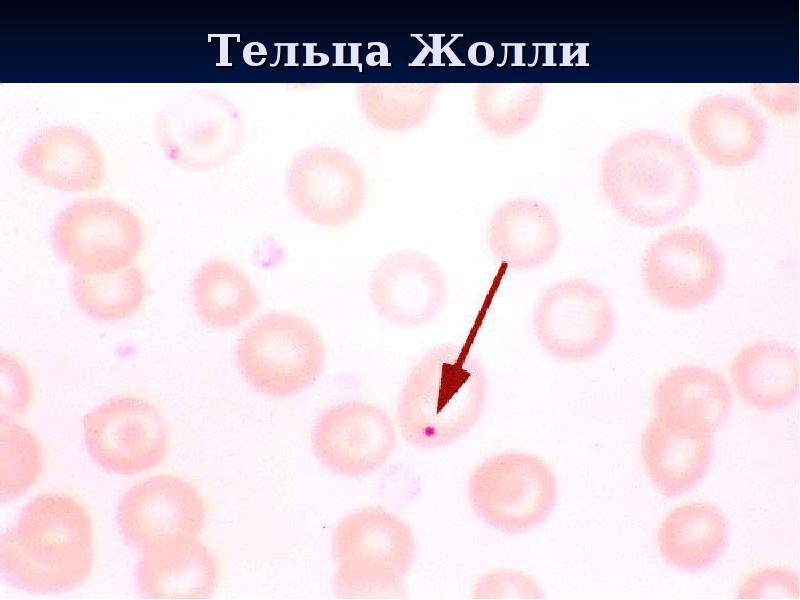
Тельца Жолли
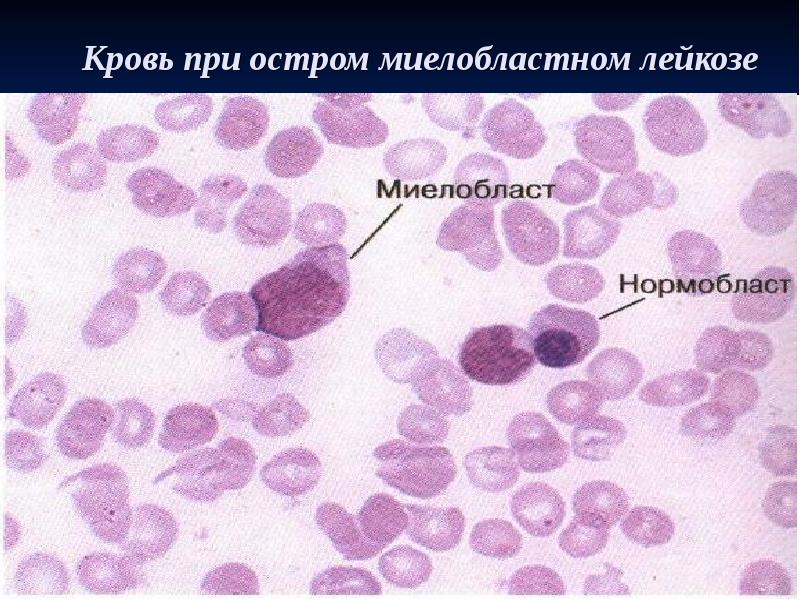
Кровь при остром миелобластном лейкозе

Анемия. Острый лейкоз. Хронические лейкозы презентация
Содержание
- 2. План лекции: План лекции: Определение анемии Классификация анемий Железодефицитная анемия: этиология,
- 3. Анемия, или малокровие - патологическое состояние, характеризующиеся уменьшением общего количества гемоглобина
- 4. Морфологические типы анемии: Морфологические типы анемии: Нормоцитарные нормохромные анемии, характеризующиеся нормальным
- 5. Патогенетическая классификация анемий Патогенетическая классификация анемий (Г.А. Алексеев, И.А.
- 6. Железодефицитная анемия (ЖДА) – состояние, характеризующиеся снижением количества железа в организме
- 7. Особенности эпидемиологии ЖДА Особенности эпидемиологии ЖДА По данным ВОЗ, во всем
- 8. Три стадии дефицита железа Три стадии дефицита железа 1. Прелатентный
- 9. Причинами дефицита являются : Причинами дефицита являются : Уменьшение поступления
- 10. Причины повышенных потерь железа а. Кровотечения в желудочно-кишечном тракте б.
- 11. Клиническая картина ЖДА: Клинические признаки анемического синдрома Клинические признаки сидеропенического синдрома
- 12. Клинические признаки анемического синдрома: бледность кожи и слизистых оболочек, иногда кожа
- 13. Вермеер Дельфтский"Служанка с кувшином молока" Вермеер Дельфтский"Служанка с кувшином молока"
- 14. Клинические признаки сидеропенического синдрома: Болезненные трещины в уголках рта: Сухая и
- 15. Сидеропенический синдром (продолжение) Нарушения функции желудочно-кишечного тракта (затрудненное глотание- Синдром Плюммера-Вильсона;
- 16. Географический язык
- 17. Изменения со стороны сердечно-сосудистой системы у больных с ЖДА: Одышка,
- 18. Лабораторная диагностика ОАК: Гипохромная микроцитарная анемия: эритроциты уменьшаются в
- 19. Снижение гемоглобина Снижение гемоглобина Низкий цветовой показатель (0,7-0,5) Количество ретикулоцитов не
- 20. ретикулоциты
- 21. Пойкилоцитоз - изменение формы Эр
- 22. Анизацитоз – изменение размеров Эр.
- 23. Железо сыворотки по методу Henry: Железо сыворотки по методу Henry: В
- 24. Коэффициент насыщения трансферрина (КНТ). Коэффициент насыщения трансферрина (КНТ). Он
- 25. Современные требования к железосодержащим препаратам: Современные требования к железосодержащим препаратам: Высокое
- 26. Главные постулаты о лечении ЖДА: Главные постулаты о лечении ЖДА:
- 27. Различают препараты железа: Различают препараты железа: 1) для приема
- 28. Препараты железа следует принимать не чаще чем через 6 ч (т.
- 29. В12-дефицитная анемия цианкобаламиндефицитная анемия, пернициозная анемия, анемия
- 30. Этиология Этиология К дефициту В12 приводят: недостаточное
- 31. Основные причины В12-дефицита ( по В.Я. Шустову, 1988) Истинная анемия Аддисона
- 32. Патогенез При дефиците В12 нарушается синтез ДНК и митотические процессы в
- 33. Клиническая картина Макроцитарно-магалобластная анемия Поражение пищеварительной системы Неврологический синдром
- 34. Проявления анемического синдрома: Бледная кожа с лимонно-желтым оттенком Субиктеричность склер Больные
- 35. Поражение пищеварительной системы: Снижение аппетита, отвращение к некоторым пищевым продуктам
- 36. Поражение нервной системы: Парестезии (чувство онемения, ползания мурашек, отсутствие чувствительности
- 37. В основе неврологической симптоматики- фуникулярный миелоз боковых и (или) задних столбов
- 38. Лабораторная диагностика: ОАК: Количество эритроцитов снижено В меньшей степени снижен
- 39. Лабораторная диагностика (продолжение) Лейкоциты снижены (нейтропения, эозинопения) Относительный лимфоцитоз.
- 40. Базофильная зернистость Эр.
- 41. Тельца Жолли
- 42. Тельца Жолли
- 43. Кольца Кебота
- 44. мегакариоцит
- 45. Дополнительные критерии: Дополнительные критерии: Повышается непрямой билирубин в крови
- 46. Лечение: Витамин В12 по 200-500 мкг/сут , в тяжелых случаях
- 47. Показатель эффективности лечения : Показатель эффективности лечения : ретикулоцитарный криз
- 48. Гематосаркомы - это заболевания, характеризующиеся опухолевым разрастанием в органах кроветворения патологически
- 49. Лейкозы: Лейкозы: острые хронические Гематосаркомы: Ретикулосаркома Лимфосаркома лимфогрануломатоз
- 50. Острый лейкоз Острый лейкоз (острая лейкемия) представляет собой злокачественную клоновую опухоль
- 53. В зависимости от морфологии и цитохимических показателей клеток в группе острых
- 54. Стадии острого лейкоза: начальная развернутая ремиссия (полная или неполная) рецидив терминальная
- 55. Начальная стадия острого лейкоза диагностируется чаще всего тогда, когда у больных
- 56. Ремиссия: Ремиссия: Полная Неполная Полная ремиссия: отсутствуют клинические симптомы заболевания,
- 57. Рецидив острого лейкоза может возникать в костном мозге или вне костного
- 58. Терминальная стадия острого лейкоза характеризуется: Терминальная стадия острого лейкоза характеризуется: резистентностью
- 59. Первые проявления заболевания носят общий характер: Первые проявления заболевания носят общий
- 60. Болезнь может начинаться остро – с катаральных изменений в носоглотке, ангины.
- 61. В развернутой стадии заболевания в клинической картине можно выделить несколько синдромов:
- 62. Геморрагический синдром встречается практически у всех больных. Геморрагический синдром встречается практически
- 63. При остром лимфобластном лейкозе При остром лимфобластном лейкозе 1) увеличиваются лимфоузлы
- 64. В периферической крови у большинства больных обнаруживается: В периферической крови у
- 65. Кровь при остром миелобластном лейкозе
- 66. Кровь при остром лейкозе (лейкемический провал)
- 67. Лечение острого лейкоза 1. Индукция ремиссии, ее консолидация 2. Поддерживающая терапия
- 68. Программа (схема), применяемая для индукции ремиссии больным ООЛ (протокол Hoelzer и
- 69. Лейкозы хронические Хронический миелолейкоз (ХМЛ) –миелоидная опухоль, возникающая на уровне полипотенной
- 70. В периферической крови выявляются все переходные формы клеточных элементов: Промиелоциты Миелоциты
- 71. Увеличение лейкоцитов до 200-300 ٭109/л Увеличение лейкоцитов до 200-300 ٭109/л Присутствие
- 72. Кровь при хроническом миелолейкозе
- 73. Принципы терапии хронического миелолейкоза В хронической фазе заболевания: Миелосан, допан,
- 74. Течение, прогноз хронического миелолейкоза Течение, прогноз хронического миелолейкоза На фоне
- 75. Хронический В-клеточный лимфолейкоз (ХЛЛ) доброкачественная опухоль из CD-5 позитивных В-клеток, первично
- 76. Клиническая картина. Клиническая картина. Синдром лимфаденопатии – увеличиваются лимфатические узлы
- 77. В крови – абсолютный лейкоцитоз (до 30-200 ٭ 109 /л) из
- 78. Кровь при хроническом лимфолейкозе
- 79. Лечение. Болезнь неизлечима современными методами. Лечение. Болезнь неизлечима современными методами.
- 80. Новые аналоги пурина: ФЛУДАРА (флударабин монофосфат),КЛАДРИБИН Новые аналоги пурина: ФЛУДАРА (флударабин
- 81. Новые перспективные лекарственные препараты Моноклональные антитела против антигенов CD19, CD20 (Ретуксан,
- 82. Прогноз при хроническом лимфолейкозе Продолжительность жизни в среднем 5-6 лет (в
- 83. Литература: Клиническая гематология: Пособие/ А.Ф.Романова, Я.И.Выговская, В.Е.Логинский./под ред. А.Д.Романовой- Киев.:Медицина,2006.-456с.
- 84. Скачать презентацию

Слайды и текст этой презентации
Скачать презентацию на тему Анемия. Острый лейкоз. Хронические лейкозы можно ниже:
Похожие презентации